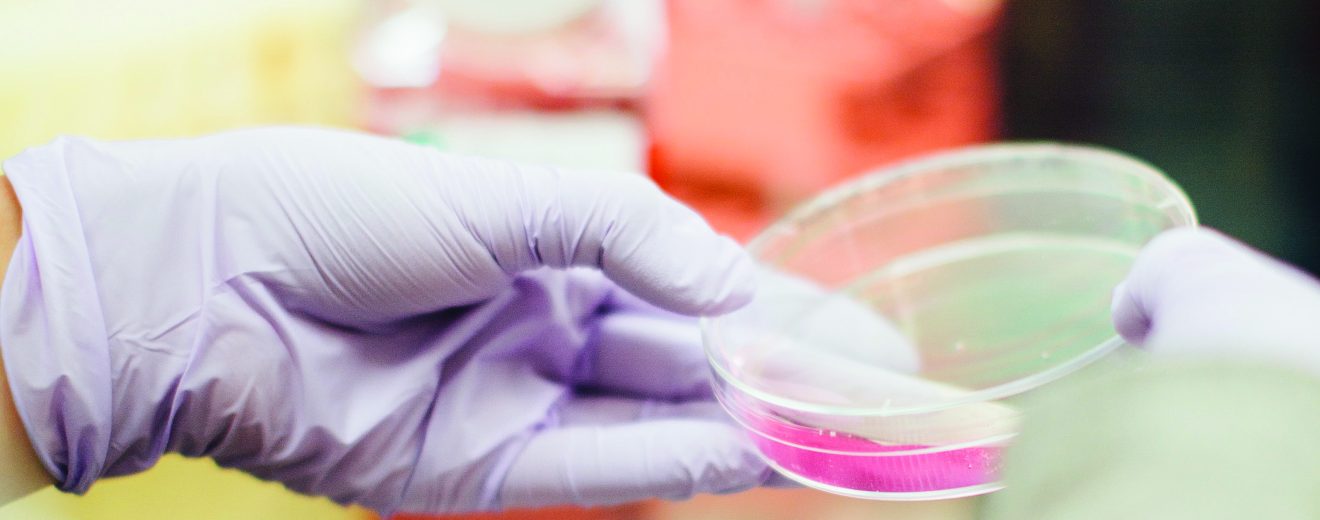

Three years ago, the world turned its attention to the bioscience industry for information and guidance on how to navigate the COVID-19 global pandemic. With the spotlight on the bioscience industry, it’s clear that this sector is vital for health security and economic growth. Strategic planning The 2021 federal budget saw the government commit $2.2 … Continue reading Biosciences 101